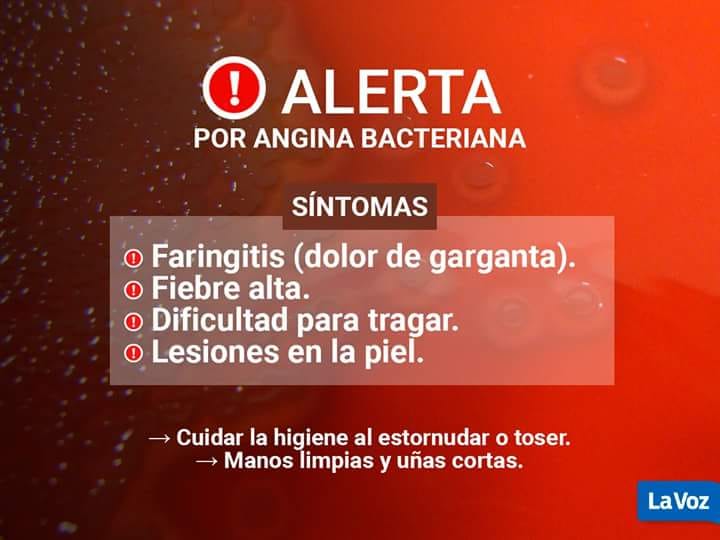
angina streptococo

Que es el estreptococo y como se previene
 Las Rosas Digital
Las Rosas Digital
Dr, Alejandro Luna por Renacer Regional
La alarma que desató el tema hizo que se abarrotaran las guardias de hospitales y sanatorios de padres preocupados por la salud de sus hijos.
Es que en esta época del año, un cuadro de fiebre o dolor de garganta es de lo más usual entre los niños, pero con la noticia en la primera plana de todos los medios de comunicación, nadie quiere demorar la consulta. Y hacen bien. Por eso consultamos al director del SAMCo Las Rosas, Dr. Alejandro Luna.
"El estreptococo generalmente convive entre nosotros. Es el responsable de la angina puntácea. Pero cuando sus niveles en sangre aumenta puede alojarse en distintos tejidos del cuerpo, y producir estos casos fatales ocasionalmente".
"El germén se contagia por vía oral. Y como síntomas la forma más frecuente es que comience como una amigdalitis. Con fiebre, dolor de garganta, dolor de cabeza, dolor de musculos y articulaciones."
Hay que acudir al médico si hay una angina roja. Y se debe ver la evolución que tiene, para recetar el uso de antibióticos, ya que es una bacteria muy sensible a la penicilina.
(Es importante escuchar el audio completo)


Expoagro 2026: el financiamiento estratégico desplaza a la "licuación" por inflación

Falleció el dirigente rural entrerriano Jorge Chemes

La tormenta severa de la pasada semana afectó 400.000 hectáreas de cultivos en la zona centro

Alerta por la venta sin control de "bolsas de nicotina" en el país.

Calendario 2026: todos los fines de semana largos y feriados puente del año

Habrá nuevos diseños y medidas de seguridad para el DNI y el Pasaporte a partir de febrero





Encontraron con vida al joven de Bigand que era buscado: cayó con su auto a un arroyo




